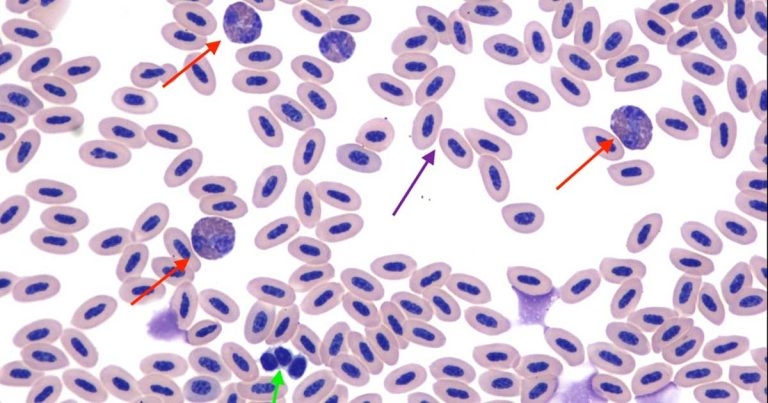
Case of a cockatoo with leukocytosis

16 Dec 2019
Francesco Cian presents the case of an eight-year-old cockatoo seen by a referring veterinary surgeon for a traumatic foot lesion.
Figure 1. Blood smear. Inset: (a) heterophil; (b) eosinophil.
Based on the data and the blood smear picture provided, try to answer the following questions.
The haematology results show mild leukocytosis, confirmed on blood smear examination by a subjective leukocyte increase in the monolayer area. In particular, heterophils (red arrows) and monocytes (not seen in the image) are increased.
Heterophilia and monocytosis indicate inflammation likely due to the traumatic foot lesion identified during the clinical examination.
In birds, heterophils are the counterparts of mammalian neutrophils. They have a colourless cytoplasm and contain characteristic dark orange to brown-red, rod or specular-shaped granules. These should be differentiated from the granules of eosinophils, which usually appear more round and are strongly eosinophilic in colour.
The cells indicated by the purple arrow are red blood cells (RBCs). In contrast to mammals, RBCs in birds and reptiles have nuclei.
The anucleated erythrocytes seen in mammals are considered more evolutionarily ‘‘advanced’’, as they are able to “squeeze” more easily through small blood capillaries and have maximum surface for haemoglobin.
Moreover, the extrusion of nuclei and mitochondria has helped mammal RBCs to better adapt to high-sugar and high-heme conditions, by limiting the formation of reactive oxygen species.
These cells are thrombocytes, which, in all birds and reptiles, are also nucleated. They appear as small, round-to-oval cells with a round nucleus and densely clumped chromatin.
The cytoplasm of normal thrombocytes is colourless to pale grey and occasionally contains one or more distinct eosinophilic granules. These features are useful in differentiating thrombocytes from small mature lymphocytes, which can appear similar.
In general, between 10 and 15 thrombocytes per 1,000 erythrocytes are considered to be an adequate number – numbers lower than that suggest thrombocytopenia.